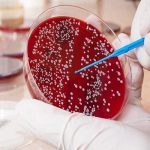

همهچیز درباره تماس تلفنی و استفاده از اینترنت در پیادهروی اربعین
به گزارش بازتاب خوزستان به نقل از فارس، همزمان با فرا رسیدن ایام پیادهروی اربعین و سفر میلیونها عاشق حسینی به کشور عراق نیاز است تا همراهان برای یافتن یکدیگر و یا برقراری ارتباط با ایران از خطوط تلفن همراه خود استفاده کنند؛ در همین راستا نیز وزارت ارتباطات عراق و ایران تمهیداتی را در نظر گرفتهاند.
اپراتور ایرانسل به منظور سهولت در استفاده از خدمات سیمکارت از جمله اینترنت پرسرعت، تعرفههای تخفیفی ویژهای برای استفاده از سرویس رومینگ با اپراتورهای کشور عراق معرفی کرده است؛ البته لازم است تا دارندگان این سیم کارتها برای استفاده از خدمات، رومینگ خود را فعال نمایند. برای این کار لازم است لب مرز کد دستوری #۱*۱۱۱۱* را از سیمکارت خود شمارهگیری کرده و یا از طریق اپلیکیشن ایرانسلمن آن را فعال نمایند.
در مناطق مرزی مهران، خسروی، شلمچه، چذابه، تمرچین و باشماق و مسیرهای منتهی به این مناطق زایران میتوانند با شمارهگیری #۱*۴۰* از یک بسته ۱ گیگابایتی رایگان با اعتبار ۷ روزه بهره ببرند. البته به این نکته باید توجه کنید که استفاده از این بسته فقط در همین نواحی امکانپذیر است و هر شماره میتواند یک بار این بسته را فعال کند.
زائران میتوانند در مناطق مرزی مهران، خسروی، شلمچه، چذابه، تمرچین و باشماق از اینترنت وایفای رایگان استفاده کنند.
برای فعالسازی آن لازم است ابتدا وایفای گوشی را روشن کرده و سپس عدد ۱ را به سرشماره ۱۱۵۵ ارسال نمایید تا رمز عبور برایتان ارسال و به شبکه وایفای متصل شوید.
بستههای رومینگ اپراتور همراه اول برای زائران
زائران عتبات عالیات در شهرهای کربلا، نجف، کاظمین و… برای کاهش هزینههای ارتباطی خود در ایام اربعین میتوانند لب مرز از طریق کد دستوری #۴۰*۱۰* اقدام به خرید و فعالسازی بستههای رومینگ ویژه اربعین کنند. امکان فعال سازی بستههای رومینگ برای کلیه سیمکارتهای حقیقی، حقوقی، دائمی و اعتباری در این ایام وجود دارد.
بنابر اطلاع اپراتور همراه اول، در بسته اینترنت رومینگ نامحدود ۷ روزه عراق، بعد از مقدار مصرف منصفانه ۳ گیگابایت سرعت مصرف به ۱ مگابایت در ثانیه میرسد ولی امکان دسترسی به شبکه دیتا تا انتهای بازه زمانی برقرار خواهد بود.
در جداول زیر هزینه بستههای مختلف آورده شده است؛ در نظر داشته باشید که هزینههای اعلام شده بدون احتساب مالیات و ارزش افزوده است.
بستههای اینترنت برای دارندگان سیم کارت رایتل
اپراتور رایتل نیز همزمان با فرا رسیدن ایام پیاده روی اربعین جهت سهولت در برقراری ارتباط برای دارندگان این سیم کارت بستههای به صرفه اینترنت در نظر گرفته است.
کاربران میتوانند برای فعال سازی رومینگ رایتل، عبارت ON IR را به شماره ۲۰۲۰ پیامک کرده و برای اطلاع از وضعیت سرویس رومینگ، عبارت VIEW IR را به شماره ۲۰۲۰ پیامک کنند. پیامک عبارت OFF IR به شماره ۲۰۲۰ نیز این قابلیت را غیرفعال خواهد کرد.
اگر بنا دارید از سیم کارت رایتل در کشور عراق استفاده کنید، این اپراتور سیم کارتهای اعتباری با شرایط ویژه به متقاضیان ارایه کرده است؛ این سیم کارتها ۳ گیگابایت اینترنت قابل استفاده در ایران، ۱۰۰ مگابایت اینترنت قابل استفاده در عراق (رومینگ بین الملل)، ۳۰ دقیقه مکالمه درون و برون شبکه در ایران و ۳۰ عدد پیامک درون و برون شبکه در ایران دارد.
تعرفههای تخفیفی رومینگ بینالملل رایتل در عراق
گفتنی است؛ این بستههای مصرفی ویژه مشترکین رایتل جهت استفاده در کشور عراق است که با اتصال به اپراتورهای (Zain، Korek) درآن کشور قابل استفاده است.
صفر تا صد سیمکارت عراقی بهعنوان روش به صرفه
یکی از گزینههای موجود برای برقراری تماس و کار با اینترنت، استفاده از سیمکارت عراقی است که در مرز و همینطور در کشور عراق بهسادگی میتوان تهیه کرد. با توجه به اینکه هزینههای استفاده ازین سیمکارت بهصرفهتر از رومینگ سیمکارت داخلی است، در طی این سالها بیشتر توصیه شده است.
عیسی زارعپور وزیر ارتباطات سه شنبه ۳۱ مرداد ماه در صحن علنی مجلس اعلام کرد که با همکاری وزیر محترم عراقی امسال سیم کارتهای عراقی و رومینگ با قیمت کمتر و کیفیت بهتر نسبت به سال گذشته در اختیار زوار قرار میگیرد.
لازم به ذکر است پیش از این اعلام شده بود که وزارت ارتباطات کشور عراق قرار است سیم کارتهای عراقی با اینترنت و تماس رایگان در اختیار زائران کشورهایی همچون ایران، عربستان، کویت و لبنان قرار دهد، اما پیگیریها نشان میدهد این موضوع بسیار محدود بوده و امکان استفاده عمومی توسط زائران وجود ندارد. بهترین گزینه، خریداری سیمکارت عراقی در مرزهاست که آسانتر و با قیمت کمتری صورت میگیرد.
توصیههای اینترنتی برای زایران اربعین حسینی
– بهتر است قبل از آغاز سفر ، سیم کارت خود را بیشتر از میزان مصرفی خود شارژ نمایید تا در صورت نیاز و یا تمام شدن بسته اینترنتی خود از شارژ سیم کارت استفاده نمایید.
– در طول سفر از شارژ سیم کارت خود مطمئن باشید، در صورتی که شارژتان رو به اتمام است از آشنایان خود در ایران بخواهید که سیم کارت شما را شارژ نماید.
– به این نکته توجه کنید که با روشن کردن اینترنت رومینگ، اینترنت مورد استفاده در اپلیکیشنهای تلفن همراه شما با هزینه رومینگ محاسبه خواهد شد، بنابراین از غیرفعال بودن اپلیکیشنهای خود اطمینان حاصل کنید.
– برای پرهیز از هزینههای غیرضروری در هنگام حضور در کشور عراق، در تنظیمات پیامرسانهای خود، دانلود خودکار ویدئو، عکس و فایل صوتی را غیرفعال کنید و تا حد امکان از اپلیکیشنهای فضای مجازی استفاده نکنید.

هیچ دیدگاهی درج نشده - اولین نفر باشید